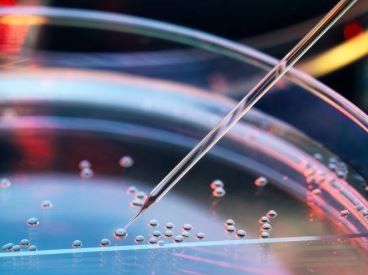

OLÁ,
SOMOS A BIOINVOLVE
A Bioinvolve é uma empresa de consultoria e treinamento especializada e instituída para oferecer soluções que agregam valor aos estabelecimentos de saúde que realizam atividades com células germinativas, tecidos germinativos e embriões humanos para uso terapêutico e que primam pela melhoria contínua da qualidade, segurança e eficácia de seus produtos e serviços.
Acreditamos que a sinergia de competências e de habilidades dos profissionais envolvidos e o compartilhamento de conhecimentos são essenciais para o sucesso.